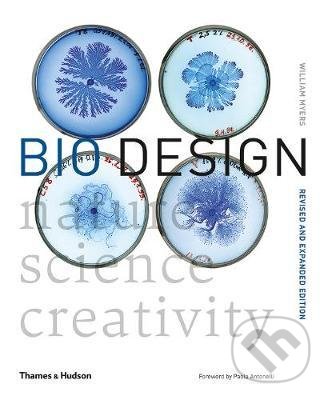
Bio Design (Nature * Science * Creativity) - William Myers - kniha z kategorie Přírodní vědy a technika

Thames & Hudson
Zobrazeno 196. – 210. z 1770 výsledků
- Dechberoucí titul z kategorie Umění, design a architektura od společnosti Thames & Hudson.Původní cena byla: 425 Kč.425 KčAktuální cena je: 425 Kč. Koupit
- Dechberoucí titul z kategorie Historie od společnosti Thames & Hudson.Původní cena byla: 1 241 Kč.1 241 KčAktuální cena je: 1 241 Kč. Koupit
- Dechberoucí titul z kategorie Historie od společnosti Thames & Hudson.Původní cena byla: 519 Kč.460 KčAktuální cena je: 460 Kč. Koupit
- Dechberoucí titul z kategorie Umění, design a architektura od společnosti Thames & Hudson.Původní cena byla: 711 Kč.539 KčAktuální cena je: 539 Kč. Koupit
- Dechberoucí titul z kategorie Umění, design a architektura od společnosti Thames & Hudson.Původní cena byla: 1 414 Kč.1 414 KčAktuální cena je: 1 414 Kč. Koupit
- Dechberoucí titul z kategorie Knihy od společnosti Thames & Hudson.Původní cena byla: 1 102 Kč.1 102 KčAktuální cena je: 1 102 Kč. Koupit
- Big Art / Small Art od Tristana Manca je unikátní pohled na svět umění, který vás provede od velkých děl klasiky až po malířské experimenty současnosti.1 065 Kč Koupit
- Dechberoucí titul z kategorie Dům, byt a zahrada od společnosti Thames & Hudson.Původní cena byla: 1 430 Kč.1 430 KčAktuální cena je: 1 430 Kč. Koupit
- Dechberoucí titul z kategorie Přírodní vědy a technika od společnosti Thames & Hudson.Původní cena byla: 779 Kč.591 KčAktuální cena je: 591 Kč. Koupit
- Dechberoucí titul z kategorie Design od společnosti Thames & Hudson.Původní cena byla: 1 455 Kč.1 455 KčAktuální cena je: 1 455 Kč. Koupit
Zobrazeno 196. – 210. z 1770 výsledků